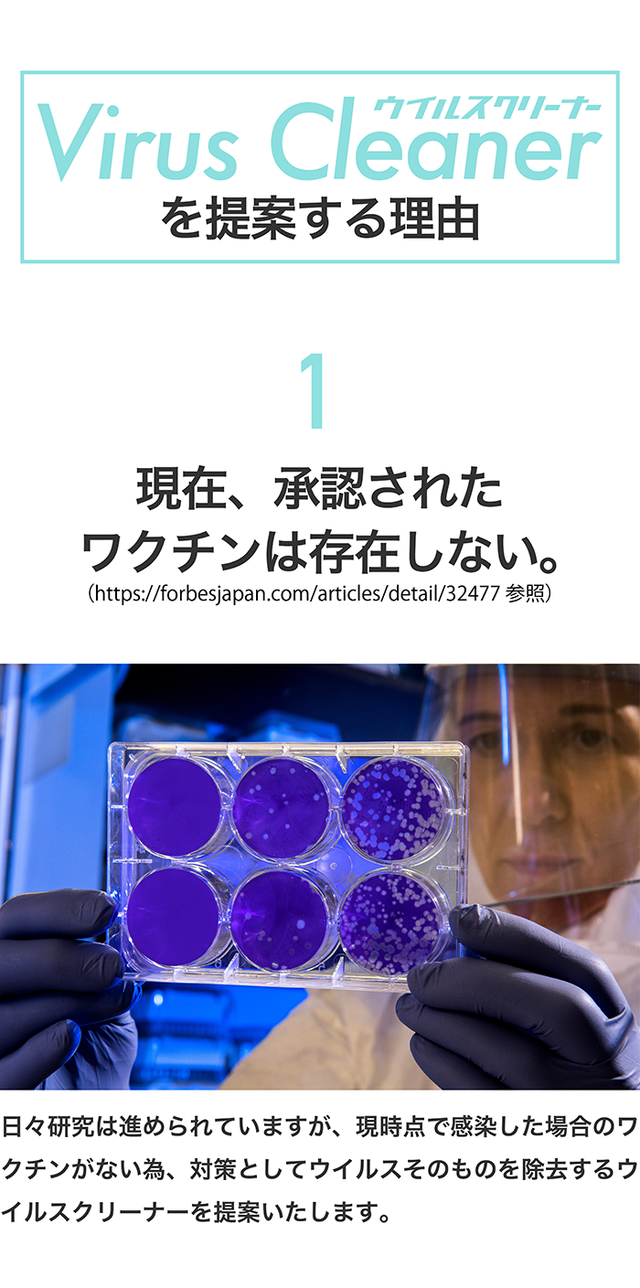

ストーリー
- 『せめて自宅やオフィスの空間だけでもウイルス除去の対策を』そんな想いにお応えします。
- 約40万円の価格にはワケがある。ウイルスへの対策は米国特許による対策で。
- ただし、このタイミングでMakuake限定4年分フィルターとご用意できるのは、"50台"だけ

リスク&チャレンジ
・発送は4月末まで予定しておりますが、天候などにより一部遅れる可能性がございますので予めご了承ください。 ・国内の独占販売権利を要しておりますが、並行輸入品が発生する可能性があります。個人輸入及び販路によっては防ぐことができない可能性がある点、ご了承願います。 ・ご注文状況、使用部材の供給状況、製造工程上の都合等により出荷時期が遅れる場合があります。 ・使用感等に関する返品・返金はお受けいたしかねます。
サポーターからの応援コメント
文章のトップに戻る
応援購入する
このプロジェクトはAll in型です。目標金額の達成に関わらず、プロジェクト終了日の2020年04月16日までに支払いを完了した時点で購入が成立します。
「Makuake(マクアケ)」は、実行者の想いを応援購入によって実現するアタラシイものやサービスのプラットフォームです。このページは、 テクノロジーカテゴリの 「【ウイルスクリーナー】今までの空気清浄機、本当にウィルス対策されていますか?」プロジェクト詳細ページです。


